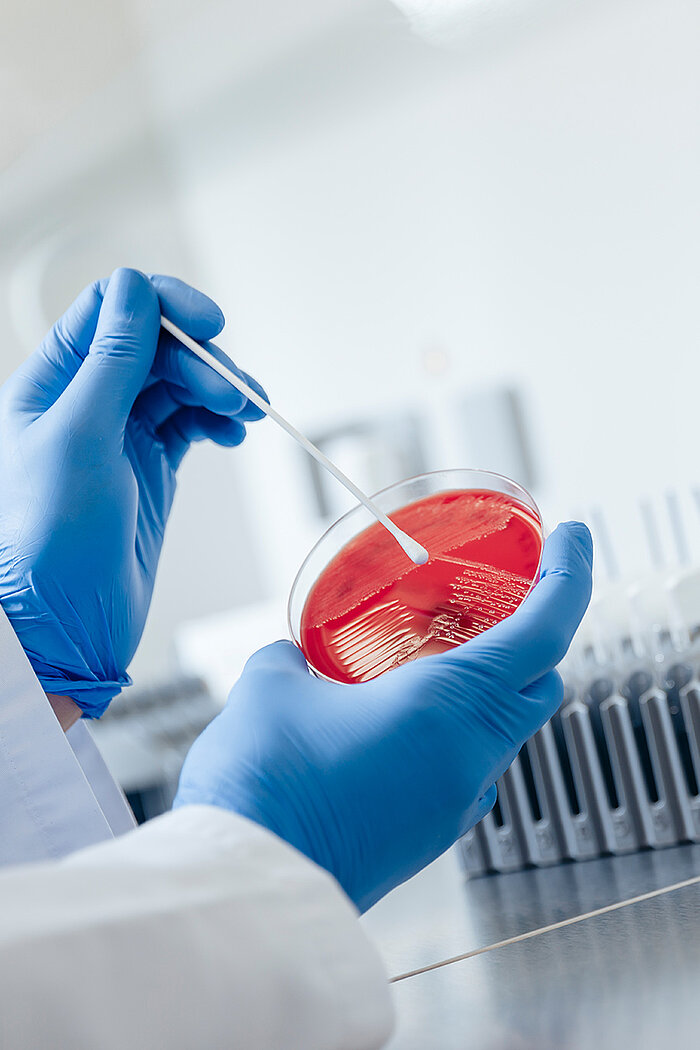
suisselab

Barbara und Stefan Gerber aus Trub BE halten Milchkühe. Während normalerweise die Kälber nach der Geburt von ihren Müttern getrennt werden, setzen Gerbers auf muttergebundene Kälberaufzucht. Kuh und Kalb bleiben sechs Monate zusammen. Das Kalb trinkt statt aus einem Kessel direkt vom Euter. Mutter und Jungtieren gehe es seit da besser, sind Gerbers überzeugt. Sie selbst nehmen einen Drittel Ertragseinbussen in Kauf. Ein neues Projekt könnte ihre finanzielle Situation aber bald verbessern.
Gegen den Trennungsschmerz der Kühe
Bilder ― Oli Hallberg, Priska Fuhrer
Text ― Julia Spahr

«Spätestens als ich selbst Mutter wurde, habe ich es kaum mehr ertragen, wenn die Kühe nach ihren Kälbern gerufen haben.»
«Spätestens als ich selbst Mutter wurde, habe ich es kaum mehr ertragen, wenn die Kühe nach ihren Kälbern gerufen haben.» Wie sie «gmöögget» haben, sagt Barbara Gerber auf Berndeutsch. Draussen auf dem Gartensitzplatz vor dem Bauernhaus sitzt sie neben ihrer Jüngsten von drei Kindern. Gegenüber ihr Mann Stefan. Der Hahn kräht, die Morgensonne strahlt die grünen Hügel um Trub BE im Emmental an. Die kühle Luft riecht nach Gras und Blumen. Bei Gerbers nimmt die ganze Familie Anteil am Geschehen im Stall. Geht es einem Tier nicht gut, beschäftigt es alle. Umso mehr sind sie darauf bedacht, dass den Tieren wohl ist. Während zehn Jahren haben sie auf ihrem 22-Hektar-Biobetrieb, den Stefan Gerber von seinen Eltern übernommen hat, Milch produziert.
Nach gängiger Praxis. Das bedeutet einerseits, dass Kühe Kälber zur Welt bringen. Denn nur wenn sie regelmässig abkalben, produzieren sie Milch. Andererseits hat es zur Folge, dass die Kälber kurz nach der Geburt von den Müttern getrennt werden. Bei Gerbers lebten die Kälber damals im Kälberstall, der noch heute im Kuhstall integriert ist und einen eigenen Auslaufbereich hat. Da wurden sie morgens und abends mit dem Eimer getränkt. Im Alter von vier bis fünf Wochen verkauften Gerbers die sogenannten Tränker. Kommen die Kälber von den Müttern weg, empfinden beide Trennungsschmerzen, sind Gerbers überzeugt. Denn die Kühe muhen und rufen nach ihren Jungen. Sie «mööggen». Das wollten Gerbers nicht mehr.

Familie Gerber auf dem Weg zur Kuhweide.
Interesse erloschen
Also änderten sie etwas. Der Milchwirtschaft sind sie treu geblieben. Sie setzen aber seit einem Jahr auf muttergebundene Kälberaufzucht (MuKa). Nach den Richtlinien von Cowpassion, dem Schweizer Verein zur Förderung der muttergebundenen Kälberaufzucht in der Milchproduktion, bleiben die Jungtiere nach der Geburt sechs Monate bei ihren Müttern. Während der ersten vier trinken sie direkt vom Euter. In den letzten beiden Monaten bekommen sie einen sogenannten Nose Flap an die Nase geklemmt, der verhindert, dass sie an die Zitze vom Euter gelangen. Von da an fressen die Kälber schon genügend Gras und Heu und brauchen keine Milch mehr. Die Nähe zur Mutter haben sie trotzdem und können sich regelmässig ablecken lassen. Kurz bevor die Kälber nach den sechs Monaten schliesslich von den Kühen getrennt werden, sei das gegenseitige Interesse weitgehend erloschen, sagt Stefan Gerber. Die Kälber sonderten sich ab, und die Mütter stiessen sie zum Teil weg. Von Trennungsschmerz könne keine Rede mehr sein, wenn die Kälber auf einen anderen Betrieb gebracht werden. Die männlichen Tiere werden im Alter von anderthalb bis zwei Jahren geschlachtet und als Weidebeef verkauft, während die weiblichen später zurück auf den Betrieb von Gerbers kommen und selbst Muttertiere werden und Milch geben.

Stefan Gerber bei einem Kalb und dessen Mutter.
«Wer dabei ist, wenn die Tiere auf die Weide gelassen werden, sieht, wie die Kälber zügig zu ihren Müttern gehen.»

Die Kälber bleiben sechs Monate bei Familie Gerber.

Während vier Monate trinken sie bei der Mutter.
Solange die Kälber bei Gerbers sind, trinken sie nicht rund um die Uhr bei ihren Müttern. Im Sommer sind sie tagsüber im Stall. In getrennten Bereichen. Am Abend, wenn die Wärme des Tages langsam der kühlen Nachtluft weicht, gehen sie mit den Kühen auf die Weide und bleiben die ganze Nacht draussen. Wer dabei ist, wenn die Tiere auf die Weide gelassen werden, sieht, wie die Kälber zügig zu ihren Müttern gehen. Sie lassen sich von der Kuh mit der grossen Zunge ablecken, suchen ihre Euter, nehmen die Zitzen in den Mund und stossen mit ihren Köpfen gegen die Euter, um die Milchproduktion anzuregen. Manchmal stehen sie mit anderen Kälbern in kleinen Gruppen, hüpfen und rennen herum, bis sie die Mütter wieder zu sich rufen. Das können sie die ganze Nacht lang machen. Kommen die Kühe, die ein säugendes Kalb haben, am Morgen, wenn die Sommertage wieder heiss werden, zurück in den Stall, sind ihre Euter meist ganz leer und werden nur kontrolliert oder noch nachgemolken. Zwölf Stunden später gehen Gerbers wieder in den Melkstand, melken alle Kühe und holen ihren Anteil.
Wobei die säugenden Mütter gelernt haben, einen Teil der Milch zurückzubehalten, um kurz darauf auf der Weide ihr Kalb mit frischer Milch zu versorgen. Mit diesem System kommen Gerbers auf deutlich weniger Milch als früher. Von den 21 Kühen der Rasse Swiss Fleckvieh molken sie vor der Systemumstellung rund 120 000 Kilo Milch pro Jahr. Da die Kälber nun viel länger bei ihnen auf dem Betrieb bleiben als früher und die ganze Nacht lang Zugang zu Milch haben, trinken sie mehr. Das führt für Gerbers zu einer Ertragseinbusse von einem Drittel. Ihre Milch kommt zurzeit als gängige Biomilch auf den Markt. 86 Rappen bekommen sie pro Kilo dafür. Dass sie nach dem MuKa-System produzieren, ist weder ausgewiesen noch im Preis abgegolten. Auch Direktzahlungen gibt es für diese Produktionsform nicht.

Langfristig nicht möglich
Was Gerbers mit der Milch momentan verdienen, wird langfristig nicht reichen. «Wir haben drei Kinder. Lange können wir das nicht so machen», sagen sie. Sie haben aber Hoffnung. Ein geplantes Projekt verspricht, die Lösung zu sein. Dazu später mehr. Sicher ist: Zurück zum alten System gehen sie nicht. Das könnten sie aus ethischer Sicht nicht verantworten. «Entweder hat es ein Tier gut, oder man hat keins», ist ihr Grundsatz. Nebst dem reinen Gewissen, das ihnen die MuKa-Haltung bringt, habe sich auch die Gesundheit der Tiere verbessert. Die Kühe hätten weniger Euterentzündungen, die Kälber seien fast nie krank, der Tierarzt müsse kaum mehr vorbeikommen.
Claudia Schneider – Tierwohlberaterin und Futtermittelbeauftragte von Bio Suisse und Demeter beim Forschungsinstitut für biologischen Landbau (FiBL) – berät Betriebsleiterinnen und -leiter in Bezug auf Systeme der kuhgebundenen Kälberaufzucht. Es gibt da unterschiedliche Systeme. Nicht nur jene, die die MuKa-Fachstelle definiert hat. Ammengebundene Haltung zum Beispiel, weshalb am Forschungsinstitut von kuh- und nicht muttergebunden gesprochen wird. Schneider weiss also Bescheid über die verschiedenen Systeme und sie sagt, dass es Kälbern auf solchen Betrieben in der Regel gut gehe. Der Zugang zum Euter und zu genügend Milch sei von Vorteil. Auf klassischen Milchwirtschaftsbetrieben sei die Milchversorgung manchmal knapp, was der Gesundheit nicht zuträglich sei. Vergleichende Untersuchungen auf Praxisbetrieben hätten allerdings ergeben, dass der Gesundheitszustand von Kälbern, die bei der Mutter trinken konnten und Kälbern, die mit dem Eimer getränkt wurden, vergleichbar gut sei.

Auch Vater Stefan Gerber und Sohn Janick geniessen es, zusammen draussen zu sein.
«Alle Kühe leiden»
Die Auseinandersetzung mit dem Trennungsschmerz sei ein wichtiger Aspekt vom kuh- und vor allem muttergebundenen Systemen, sagt Schneider. Wenn ein Kalb nach der Geburt bei der Mutter bleibt, findet die Prägung statt und dann werde es schwer, sie zu trennen. Nach etwa drei Tagen erkennt die Kuh ihr Kalb am Geruch und an der Stimme. Dann sei der Trennungsschmerz schon da. «Es leiden alle Kühe. Die einen laut, die anderen leise», sagt sie. Wie es sich auf kuh- und muttergebundenen Betrieben verhalte, sei unterschiedlich. Jedes Tier, jedes System, jeder Hof seien anders. Wer die kuhgebundene Haltung für sich in Betracht ziehe, sollte sich der verschiedenen Herausforderungen bewusst sein. «Nicht alle Rassen oder Kühe können zum Beispiel gleich gut damit umgehen, dass an ihren Eutern gesaugt wird und dass sie gemolken werden.» Allgemein sei ein Vorteil des Systems, dass sich Bäuerinnen und Bauern dadurch mit den Tieren und ihren Bedürfnissen befassen. Und auch für die Menschen mache diese Haltungsform Spass. Davon ist sie so überzeugt, dass sie in Tägertschi BE nicht wie Gerbers einen MuKa-Betrieb führt, aber einen, auf dem die Kälber an Müttern und Ammen aufgezogen werden.
Gute Hygiene
Bei Familie Gerber schien es bei der Umstellung keine Probleme gegeben zu haben. Die Kühe lassen ihre Kälber saugen und den Bauer melken. Auch hygienische Probleme gab es bei ihnen nicht. Die Zellzahl, die als Bewertungskriterium für die Rohmilchqualität gilt und einen gewissen Wert nicht überschreiten darf, sei seit der Umstellung auf MuKa sogar niedriger geworden. Das zeigt die sogenannte Milchleistungsprüfung (MLP), die auf Milchwirtschaftsbetrieben ein Mal pro Monat durchgeführt wird (siehe Beitrag zu Suisselab). Dass die Milchqualität nicht schlechter wird, decke sich mit allgemeinen Forschungserkenntnissen, wie Schneider sagt. Wenn die Betriebsleiterinnen und Betriebsleiter sauber arbeiteten, sei die Hygiene genauso gewährleistet wie in anderen Systemen.

Noch nicht lange legal
Diesbezüglich herrschen aber noch heute Vorurteile. Das kann daran liegen, dass MuKa-Haltung lange Zeit in der Schweiz nicht wirklich praktikabel war, weil die rechtliche Grundlage dazu fehlte. 2018 reichte die SP-Nationalrätin Marina Munz eine Motion ein, in der sie Klarheit forderte. Die Motion wurde angenommen und seit da können MuKa-Betriebe ihre Milch in gängige Kanäle liefern. Das Problem daran ist, dass sich das wie im Fall von Gerbers finanziell nicht lohnt. Dagegen will Evelyn Scheidegger, Gründerin und Präsidentin von Cowpassion, etwas tun. Und damit kommen wir zum vorher erwähnten Projekt, auf das Familie Gerber wartet. Scheidegger ist Betriebswirtin und «landete» durch ihren Mann – einen Bauern – auf einem Hof im Emmental, wie sie sagt. Vor fünf Jahren stellten sie auf Muka-Haltung um. Sie merkte, dass es von Seiten der Konsumentinnen und Konsumenten ein Interesse gibt an Produkten aus dieser Haltungsform. Deshalb initiierte sie ein Käse-Abo mit den Produkten aus MuKa-Milch von Hofkäsereien. Sie konnte einen guten Kundenstamm von rund 600 Personen aufbauen. Das Sortiment war aber sehr klein.
Letztes Jahr lancierte sie deshalb ein Crowdfunding, um eine Käserei zu gründen. Das war erfolgreich. 2024 soll sie im Emmental stehen und darin soll eine breitere Palette Käse aus MuKa-Milch hergestellt werden. 10 bis 15 Milchbetriebe sollen dereinst ihre Milch dorthin liefern können. Scheidegger rechnet mittelfristig mit einer Milchmenge von 1,5 Millionen Kilo, die sie pro Jahr verarbeiten wollen. Der Käse soll über Abos und eventuell in Läden verkauft werden. Bäuerinnen und Bauern sollen einen Milchpreis von Fr. 1.30 erhalten. Genau so viel also, damit die Ertragseinbussen von einem Drittel wieder reinkommen. «Nur wenn es sich für die Bauernfamilien finanziell lohnt, können sie langfristig diesen Weg gehen», sagt sie. Wie der Erfolg des Käseabos gezeigt hat, sei eine gewisse Kundschaft bereit, den höheren Preis zu bezahlen. Ausserdem zeigt ein Blick ins Ausland, dass das Bedürfnis nach MuKa-Produkten auch in anderen Gegenden besteht. In Österreich, England und Neuseeland gebe es ähnliche Projekte wie die Käserei im Emmental. Besonders weit sei man in Deutschland. Dort gibt es in den Grossverteilern Rewe und Edeka die sogenannte «Milch aus Elternzeit» zu kaufen.

Elin Gerber und ihrem Bruder Janick schmeckt die hofeigene Milch.
In der Schweiz ist die geplante Käserei die erste ihrer Art. Scheidegger hofft, dass sie eine Signalwirkung hat und weitere Projekte folgen werden. Sie hat den Eindruck, dass es einige Bauernfamilien gibt, die gern nach dem MuKa-System produzieren würden, wenn sie einen guten Milchpreis bekämen. Momentan sind unter den rund 17500 Milchwirtschaftsbetrieben in der Schweiz gerade mal 20 MuKa-Höfe. «Diverse weitere befinden sich im Umstellungsprozess», sagt Cornelia Buchli von der Fachstelle MuKa. Familie Gerber ist den Weg bereits gegangen. Sie wird ihre Milch in die Käserei im Emmental liefern und einen kostendeckenden Milchpreis erhalten. Sie sind glücklich. Darüber, dass sie ihrem System treu bleiben können und ihre Kühe nicht mehr «mööggen» hören müssen.
Weitere Infos zum Käseabo und der geplanten Käserei auf:
‣ cowpassion.ch
Ein Verzeichnis mit MuKa-Betrieben und Verkaufsstellen auf:
‣ mu-ka.ch

Von tanzender Milch
Text ― Julia Spahr
Bilder ― Ruben Ung
Suisselab hat sich im Auftrag der Zuchtverbände und der Milchbranche der Prüfung der Milch verschrieben. Sie sichert damit nicht nur die Qualität der Milch in der Schweiz, sondern tut auch etwas fürs Tierwohl. Zudem kann sie Bäuerinnen und Bauern verraten, ob ihre Kuh trächtig ist.

Erfassen und Sortieren der Milchproben.
«Die MLP sorgt einerseits für das Wohl der Tiere und andererseits ist sie eine Qualitätssicherung der Milch.»
Es sieht aus, als würden sie tanzen. Oder zumindest sehr dynamisch und synchron hintereinander heranlaufen. Die kleinen hohen Plastikfläschchen gefüllt mit weisser Flüssigkeit sind aber nicht zum Tanzen auf das Fliessband gereiht. Das hat alles einen anderen Sinn. In den Fläschchen befindet sich Milch von unterschiedlichen Bauernbetrieben aus der ganzen Schweiz. Das Milch-Ballett findet im Erdgeschoss eines Gebäudes in Zollikofen BE statt. Während heute in Zollikofen weniger Landwirtschaft betrieben wird als früher, kann der Ort auch jetzt noch als eine der landwirtschaftlichen Hauptstädte der Schweiz bezeichnet werden. Weil die Hochschule für Agrar-, Forst-, und Lebensmittelwissenschaften und gleich mehrere bedeutende Organisationen wie IP-Suisse, Swissgenetics, Swissherdbook dort ansässig sind.

Proben auf dem Weg zur Analyse.

Abpipettieren für die Analyse.
«Unsere Rolle ist das Monitoring. Wir haben klare Vorgaben, wann wir eine Grenzüberschreitung melden müssen.»
Und Suisselab. Das ist die Organisation, bei der pro Jahr 4,5 Millionen kleine Milchfläschchen aus der ganzen Schweiz übers Fliessband wandern. Für jeden Milchwirtschaftsbetrieb wird rund einmal im Monat die sogenannte Milchleistungsprüfung (MLP) durchgeführt: Das macht Suisselab im Auftrag der Zuchtverbände Swissherdbook, Braunvieh Schweiz und Holstein Switzerland. Dafür wird die Milch jedes einzelnen Tieres untersucht und die Ergebnisse werden via die Zuchtverbände an den Betriebsleiter gemeldet. Das lässt einerseits Rückschlüsse zur Fütterung der Kühe zu. Andererseits werden etwa die Zellzahlen analysiert. Ist dieser Wert erhöht, kann er Bauern und Bäuerinnen Erkenntnisse über die Tiergesundheit bieten. Es könnte sein, dass bei der Kuh eine Euterentzündung, eine Mastitis, vorliegt. Die Bauern müssen sie also behandeln. Falls die Kuh den vorgegebenen Richtwert zu den Zellzahlen überschreitet, können Landwirtinnen die Milch nicht in den allgemeinen Milchtank melken, von wo aus sie zur Verarbeitung in die Industrie geht, und später in die Läden kommt.
Sie müssen zuerst schauen, dass die Kuh wieder gesund wird und die Zellzahlen die entsprechende Grenze nicht mehr überschreiten. Christian Beck, Geschäftsleiter von Suisselab, und Daniel Glauser, Tierarzt und Leiter der veterinärmedizinischen Diagnostik, sitzen vor dem Suisselab-Gebäude bei einem Kaffee. Mit etwas Milch. Die MLP sorge einerseits für das Wohl der Tiere, sagt Beck. Herdemanager wüssten dank der Prüfung Bescheid über die Eutergesundheit der Tiere und könnten allfällige Probleme schnell beheben. Andererseits sei es eine Qualitätssicherung der Milch. «Grundsätzlich bestätigt unsere Arbeit, dass in der Schweiz auf sehr hohem Niveau Milch produziert wird», sagt Beck.

Pipettierung Fertalys – Trächtigkeitstest.
Ausstreichen der Proben für MID-Analysen.
Das zeige auch die Milchprüfung (MP), die nebst der MLP durchgeführt wird. Zwei Mal im Monat. Hier werden Proben des ganzen Milchtanks genommen und nicht von jedem einzelnen Tier. Auch da geht es darum, die Qualität sicherzustellen, und es können Erkenntnisse darüber gewonnen werden, wie viel Fett, Eiweiss und Laktose die Milch enthält, was letztlich Auswirkungen auf die Höhe des Milchpreises hat. Die Durchführung der Milchprüfung entspricht den rechtlichen Vorgaben der bilateralen Verträge mit der EU und sichert somit die Exportfähigkeit. Über beide Prüfsysteme sagt Beck, dass Suisselab nicht als eine Art Aufpasserinstanz verstanden werden wolle, selbst wenn das Wort «Prüfung» streng töne. «Unsere Rolle ist das Monitoring. Wir haben klare Vorgaben, wann wir eine Grenzüberschreitung melden müssen.» Es könne zum Beispiel sein, dass im Rahmen der Milchprüfung Hemmstoffe angezeigt werden. «Wenn Suisselab die ermittelt, hat sie den Auftrag, es nach Verifizierung und bestätigtem Ergebnis den Behörden zu melden», sagt Beck. Das komme aber nur sehr selten vor. Suisselab bietet nebst den Programmen auch individuelle Analysen an. So kann der Tierhalter mehr über die Milchgehalte von einzelnen Tieren erfahren, aber auch vertiefte Analysen erstellen lassen.
Die Mastitis-Identifikation hilft etwa dabei, mögliche Antibiotikaresistenzen festzustellen, was zu tierschonender, zielgerichteter Medikation und damit auch zur Reduktion des Antibiotika-Einsatzes dient. Besonders stolz zeigen sich Beck und Glauser über Fertalys: «Im Juli dieses Jahres konnten wir den zwei millionsten Test durchführen», sagt Tierarzt Glauser. Fertalys ist ein Schwangerschaftstest für Kühe, könnte man sagen. Ist ein Tier trächtig, lässt sich in der Milch ein von der Plazenta produziertes Eiweiss feststellen, das bestätigt, dass die Kuh in anderen Umständen ist. Beck und Glauser nehmen noch einen Schluck Kaffee und gehen zurück an die Arbeit. Besucherinnen und Besucher dürften beeindruckt nach Hause reisen. Beeindruckt darüber, wie organisiert diese Qualitätsprüfung in der Schweiz abläuft, und darüber, was sich dem Getränk, das wir oft so gedankenlos in den Kaffee oder übers Müsli giessen, alles entnehmen lässt.








